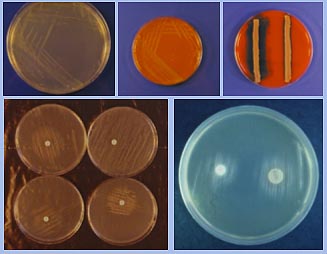
Agar

| El Haemophilus
parasuis fue descrito inicialmente como H. suis
y, redenominado más tarde, como H. influenzae suis
(Leece, 1960), siendo finalmente denominado H. parasuis
en función de su independencia,
para crecer, del factor X de coagulación de la sangre
(hemina u otras porfirinas). No obstante, su
posición actual dentro de la familia Pasteurellaceae,
género Haemophilus, al que se adscribe,
permanece incierta, debido a una
clara falta de homología con otras especies del mismo
género. Por otra parte, aunque fenotípicamente
H. parasuis es homogéneo, existe una heterogeneidad
intraespecífica muy clara, que se manifiesta no solo
desde el punto de vista inmunológico, sino también
genético. No resulta descabellado pensar, por ello, que
en un próximo futuro se produzca una reorganización
taxonómica que conduzca a decisiones drásticas
en lo que a la definición de la especie se refiere. En
ella parece probable que los serotipos 4 y 5 se organicen como
especies independientes. |
H.
parasuis se presenta como pequeños bacilos o
cocobacilos acusadamente pleomórficos, con ocasional
presencia de formas filamentosas.
Su longitud, por ello, resulta extremadamente variable,
desde 1 a 7 µm de largo por 0'2 a 2 µm de ancho.
Son microorganismos
Gram negativos, con cápsula o sin ella (según
los serotipos y, aún, según las cepas) en
cultivos de laboratorio, y dependientes para su crecimiento
del factor V de coagulación de la sangre (nicotinamida
adenina dinucleótido, NAD).
|
|

Figura 2. Tinción de Gram y Microscopías
electrónicas de barrido y transmisión de
H. parasuis.
|
Figura 3. Arriba, agar PPLO y
en el centro agar sangre inoculados con H. parasuis. A la
derecha agar sangre inoculado con A. pleuropneumoniae y
H. parasuis. En todos los casos, medios con NAD. Abajo,
agar TSA con discos de NAD, a la izquierda, detalle del
crecimiento de A. pleuropneumoniae, A. suis, (arriba) y
H.parasuis y A. minor (abajo). A la derecha, A. pleuropneumoniae
en agar PPLO con discos de NAD.
|
|
En el laboratorio, para
su crecimiento y cultivo, se añade ß-NAD a
los medios de cultivo, en una proporción aproximada
del 0'01-0'025 %. De forma natural, el factor se obtiene
directamente en algunas formulaciones que incorporan sangre
calentada (agar chocolate) o mediante la utilización
de estrategias de cocultivo, con una estría nodriza
de otras bacterias productoras del factor, como Staphylococcus
aureus o St epidermidis, a las que satelitiza
en la superficie de los cultivos. Producen colonias muy
pequeñas, de 0'5-1 mm de diámetro (e incluso
menos), no hemolíticas sobre agar sangre (lo que
les diferencia de Actinobacillus pleuropneumoniae,
Streptococcus suis y otros) y traslúcidas,
después de 24-48 horas de incubación (incluso
18 horas) a 37ºC en atmósfera aerobia o, en
el caso de aislamientos o cultivos primarios, mejor en microaerofilia,
con un 5% de CO2. Los investigadores japoneses utilizan,
con éxito, el medio HN-S (en caldo o agar), preparado
a base de BHI suplementado con un 5% de suero de pollo y
NAD y adicionado, según el caso, de agar.
|
| Bioquímicamente
H. parasuis se caracteriza por una actividad metabólica
discreta, en la que destacan la presencia de las enzimas catalasa
y oxidada, careciendo, sin embargo, de ureasa. Reducen
los nitratos a nitritos, pero ni producen indol del triptófano,
ni descarboxilan la ornitina, la lisina o la arginina. Producen
ácido de diversos sustratos como la glucosa, manosa,
maltosa y sacarosa, pero son negativas en el caso de la xilosa,
lactosa, manitol, rafinosa y arabinosa. En el caso del inositol
se obtienen resultados variables según la cepa de estudio,
igual que ocurre con la producción de SH². |
|
Determinación
|
Resultado
|
Determinación
|
Resultado
|
|
Necesidad de NAD
|
+
|
Acido de arabinosa
|
-
|
|
Hemólisis
|
-
|
Acido de melibiosa
|
-
|
|
CAMP
|
-
|
Acido de trehalosa
|
-
|
|
Ureasa
|
-
|
Acido de celobiosa
|
-
|
|
Oxidasa
|
+
|
Acido de rafinosa
|
-
|
|
Catalasa
|
+
|
Acido de lactosa
|
-
|
|
ONPG
|
+
|
Acido de manitol
|
-
|
|
a-Fucosidadasa
|
+
|
Acido de la glucosa
|
+
|
|
Producción de indol
|
-
|
Acido de la manosa
|
+
|
|
Crecimiento en agar MacConkey
|
-
|
Acido de la manosa
|
+
|
|
Reducción de Nitratos
|
+
|
Acido de la maltosa
|
+
|
|
|
|
Acido de la sacarosa
|
+
|
| Tabla 1.
Características metabólicas principales de H.
parasuis |
| Diferenciación intraespecífica
de H. parasuis |
| Dentro
de H. parasuis se acumulan una ingente variedad de cepas
entre las que, al menos desde el punto de vista práctico
y en lo que a la patogenicidad se refiere, existen diferencias
considerables. Algunas, se relacionan
con procesos morbosos en tanto que otras pasan por ser comensales
del tracto respiratorio superior del ganado porcino.
Estas diferencias, no
pueden ponerse de manifiesto desde el punto de vista metabólico
y, desde hace ya años, los especialistas se esfuerzan
por establecer relaciones inmunológicas moleculares,
genéticas o fenotípicas, al menos en alguna
medida, entre ciertos caracteres y la capacidad para producir
daño en el hospedador. |
En este sentido, por ejemplo,
aplicando métodos electroforéticos
(electroforesis en geles de poliacrilamida, SDS-PAGE), Nicolet
y Morozumi (1980, 1986) pusieron de manifiesto dos
patrones diferentes sobre los que asentaron biotipos, denominados
con números romanos (I y II). El biotipo I
se caracteriza por la presencia de grupos de bandas con
PM por encima de 68 kDa y entre 23 y 40 kDa y agrupa, por
lo general, cepas de H. parasuis que se aislan de
las fosas nasales de cerdos sanos o de origen respiratorio
en general. El biotipo II, se caracteriza
por la presencia de una banda de aproximadamente 37 kDa
de PM y es él se corresponden cepas que producen
enfermedad de Glässer.
|
|
Figura 4: Perfiles SDS-PAGE
en los biotipos I y II (Nicolet et al.)
|
| En un estudio realizado en
Japón, se concluyó que el 80% de las cepas de
origen nasal eran del biotipo I, mientras que el 91% de las
cepas aisladas de casos de enfermedad (lesiones) eran del biotipo
II. |
Se
ha aplicado, también, un método similar para
estudiar los perfiles de las proteínas de membrana
externa (PME) a partir de preparaciones de suspensiones de
bacterias rotas por ultrasonidos. Mediante este procedimiento,
se han llegado a diferenciar hasta 18 patrones diferentes,
que ratifican la gran variabilidad
intraespecífica, ya comentada.
Finalmente, las cepas se han discriminado dentro
de H. parasuis, por su reacción
frente a antisueros policlonales obtenidos en conejo.
Este es, sin duda, un procedimiento muy antiguo, iniciado
ya en 1952 con un esquema muy simple que solamente reconocía
cuatro serotipos (A, B, C y D) diferenciados por una reacción
de precipitación frente a extractos celulares. En los
años siguientes, en particular en las décadas
de los años ochenta y noventa, se fueron incorporando
descripciones de nuevos serotipos, inicialmente hasta 7 (serotipos
1 al 7), mediante un procedimiento de gel-difusión.
Las cepas asociadas con la enfermedad
de Glässer se correspondían con los serotipos
1, 5, 6 y 7, mientras que los serotipos 2 y 3 se asociaban
con neumonía y el 3 (capsulado) se consideraba comensal.
A esta lista se fueron incorporando también otros,
como los denominados "tipos Jena 6 a 12", propuestos
por Kielstein en Alemania.
|
Finalmente, en 1992, Rapp-Gabrielson
y Kielstein sentaron las bases del
esquema actual y "oficializaron" una lista de
15 serotipos que son los que se reconocen en la actualidad
(1 al 15) mediante una prueba simple de inmunodifusión
en gel en la que se enfrentan antisueros producidos en
conejo con un antígeno termoestable y resistente
a enzimas proteolíticas, probablemente de
naturaleza polisacárida o lipopolisacárida,
presumiblemente de origen capsular o mezclas de cápsula,
lipopolisacárido y algunas proteínas.
|
|
Figura 5:
Inmunodifusión para la tipificación de
H. parasuis. Detalle de las lineas de precipitación
entre los antisueros frente a los serotipos 2 y 5 y
los antígenos correspondientes (Morozumi y Nicolet)
|
|
En cualquier caso, es
destacable, que el procedimiento dista mucho de ser el ideal,
pues un número elevado de aislamientos (hasta el 30%
e incluso más) identificados como H. parasuis,
no se tipifican por los procedimientos descritos, lo que se
ha interpretado como que tales cepas tal vez no expresen suficiente
cantidad de antígeno o que, seguramente más
probable, se trate de serotipos nuevos. A estos inconvenientes
se suman otros, como la presencia de reacciones cruzadas,
la escasa inmunogenicidad de algunos serotipos, en particular
el 7 y el 9, o la gran variabilidad que presentan las cepas
incluídas en otros.
Además de los intentos de clasificación
en biotipos por SDS-PAGE, ya comentados, se han propuesto
algunas otras alternativas moleculares
para la tipificación intraespecífica de H.
parasuis, como es el caso de la electroforesis de enzimas
multilocus (MEE) propuesto recientemente por autores australianos,
que a la vez que han permitido comprobar que la cepa del serotipo
5 tiene muy poco que ver con el resto, asemejándose
únicamente a algunas cepas de los serotipos 4, 13 y
otras NT, permitió obtener buenos resultados de discriminación
y agrupación con criterios epidemiológicos,
pero resulta un procedimiento demasiado complejo para su utilización
rutinaria en los laboratorios de diagnóstico.
Otros procedimientos aplicados a la clasificación
y tipificación de cepas incluyen el RFLP (Restriction
Fragment Lengh Polymorphism), y variantes de la PCR (Polymerase
Chain Reaction), como la RAPD-PCR (Ramdomly Amplified
Polimorphic DNA) o el rep-PCR (repetitive element sequence-based),
todas las cuales han ratificado la gran heterogeneidad interna
de esta especie.
|
| Es, hasta la fecha, una
cuestión poco conocida, tal vez porque todavía
no se ha abordado con el interés suficiente por parte
de los investigadores. Un hecho evidente,
sin embargo, es la relación existente entre la virulencia
de una cepa y su serotipo, aunque extraer conclusiones
definitivas tal vez sea un tanto arriesgado pues no es raro
que un serotipo virulento incluya cepas avirulentas, y lo contrario.
|
|
Los primeros estudios desarrollados en
el hospedador natural, sugirieron que los serotipos
(mejor, las cepas de referencia de los serotipos) 1
y 5 eran virulentas y que los serotipos (cepas de referencia)
2, 3, 4, 6 y 7 eran poco virulentos o avirulentos.
Cuando la lista de serotipos se amplió a los 15 que
se conocen actualmente, también
se consideraron muy virulentos los serotipos 10, 12, 13 y
14, mientras que a la lista de menor virulencia o avirulentos
se añadieron el 8 y el 15. Así pues,
ahora se considera que los serotipos
1, 5, 10, 12, 13 y 14 se asocian con casos agudos que producen
alta mortalidad después de un curso breve de
no más allá de 4 días. Otros, como ocurre
con los serotipos 2, 4 y 15, dan lugar
a formas crónicas con artritis y poliserositis. El
serotipo 8 se califica como 'debilmente virulento' y el resto,
serotipos 3, 6, 7, 9 y 11 no se relacionan con enfermedad
clínica.
Lo que parece claro es
que el serotipo 5 es el más virulento y el que se considera
referente de patogenicidad en todos los estudios. En
el extremo contrario, también parece que hay unanimidad
respecto de la falta de virulencia de los serotipos 3, 6 y
7. Las grandes discusiones se producen
respecto de los serotipos 2 y 4.
En el primer grupo, de serotipos 'virulentos',
también se han establecido diferencias en relación
con la infección experimental
en cobayo, por vía intratraqueal, animal que se considera
un buen modelo de laboratorio. Así, los serotipos 1
y 5 resultan los más invasivos, originando la muerte
de los animales a dosis altas (1'3 x 1010 UFC, en el caso
del serotipo 1 y de 4'2 x 109 UFC en el caso del serotipo5),
mientras que en dosis más bajas (1'3 x 108 UFC en el
caso del serotipo 1 o 4'2 x 107 UFC, en el caso del serotipo
5) producían estados de septicemia persistente. En
este estudio, los serotipos 2 y 6 resultaron menos virulentos,
aunque en algunos casos fueron causa de bronconeumonía
y muerte. Finalmente, los serotipos 3, 4 y 7, solo produjeron
signos transitorios y lesiones mínimas.
La razón de la virulencia, esto es los
factores de virulencia se conocen
poco y mal, por el momento.
|
| Por
ejemplo, un hecho no aclarado, es la relación que se
aprecia entre la virulencia y la capacidad aglutinante en acriflavina,
o por simple hervido, o el perfil obtenido en SDS-PAGE del biotipo
II, que seguramente se relaciona con estructuras o funciones,
buenos candidatos para ser considerados como factores de virulencia,
aunque por el momento aun no se han definido. En relación
con la presencia de cápsula, aunque los primeros datos
apuntaron a una composición homogenea, lo cierto es que
pronto pudo verse que existían diferencias considerables,
no solo en composición, sino incluso en lo que a presencia
o ausencia se refiere;de hecho parece que más de la mitad
de los aislamientos son acapsulados y curiosamente esto parece
que coincide, también, con las cepas más virulentas.
|
|
Figura 6.
Aglutinación con acriflavina. A la izquierda, negativo
y en el centro y derecha, positivos de distinta intensidad
(Morozumi y Nicolet)
|
| La falta de cápsula
se relaciona con la aglutinabilidad, tanto en presencia de acriflavina,
como por hervido. La falta de cápsula se relaciona con
la virulencia, aunque también se han descrito cepas virulentas
capsuladas. |
También
se han asociado diferencias en la virulencia con determinadas
proteínas de la membrana externa. En un estudio reciente,
los perfiles de las PME de un grupo de cepas relacionadas con
procesos sistémicos sugirió una cierta clonalidad
de las mismas, dada la estrecha homogeneidad observada, y una
más que probable implicación como factores de
virulencia o como marcadores.
De modo particular, desde 1995 se dispone de evidencias acerca
de la existencia de proteínas receptoras de transferrina,
que tan importantes papeles desempeñan en otros microorganismos
próximos como A. pleuropneumoniae, H. influenza
y N. meningitidis (entre otros). Recientemente, trabajos
de nuestro grupo (Rodríguez Ferri et al.) han
demostrado la existencia de los genes tbpA y tbpB
que codifican para las proteínas correspondientes, receptoras
de transferrina sérica porcina y otro tanto ocurre, también,
respecto de los otros genes que forman parte del complejo TonB
(exbB y exbD). Esto no excluye, de la existencia
de otros mecanismos alternativos de captación de hierro,
como pueden ser sideróforos. |
|
En lo que
hace referencia a la presencia y participación de otras
estructuras en la virulencia como ocurre con las fimbrias, que
desaparecen cuando se cultivan en medios inertes sólidos,
su posible papel en la adherencia de la bacteria a las células
o superficies inertes, aún no ha sido establecido de
forma concluyente.
Respecto del LPS, por el momento sus patrones
moleculares no se han asociado con la virulencia, aunque se
ha relacionado con la aparición de trombosis y coagulación
intravascular diseminada.
Hace unos pocos años se ha denunciado
la presencia de la enzima neuraminidasa, independiente del
calcio, asociada a las células, en particular de forma
importante al final del periodo de crecimiento logarítmico,
sugiriéndose que su función podría relacionarse
con la supervivencia intracelular, con la adherencia celular
o, tal vez, con la captación de nutrientes.
|
Imprimir
|